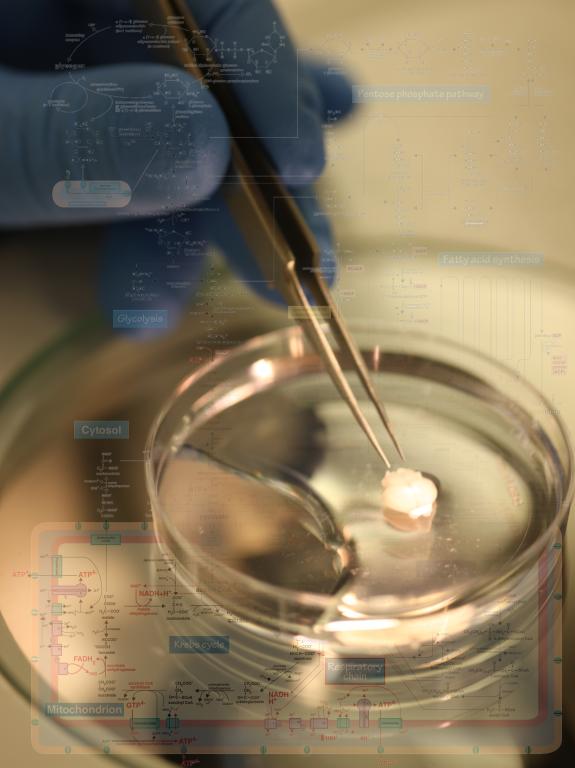

赞
赞
的个人主页 http://shi.cqjj8.com/zhoubing/zh_CN/index.htm
周炳,博士生导师,北京亚洲成人在线一二三四五六区精准医疗与大数据高精尖中心医工百人,校青年拔尖人才杰青类。2005进入上海交大医学院医学院,2009年博士毕业后于美国国立健康研究院(NIH)下属的神经疾病与脑卒中研究所(NINDS)从事科学研究工作,主要集中于研究神经元线粒体和内体/溶酶体等细胞器的轴浆转运。过去的研究揭示和阐明了几个领域内的重要问题,包括:(1)发现了成年神经元再生能力低下的内在机制,提出调节线粒体能量代谢是促进神经再生的理想治疗靶点。 (2)揭示了ALS疾病的重要病理机制,证明溶酶体异常导致受损线粒体无法通过Mitophagy途径进行降解,是神经元出现病理改变和导致症状发生的重要因素。主要学术成果发表在Neuron、Journal of Cell Biology、Cell Reports、Autophagy等,其学术成果受到包括新英格兰医学杂志在内的广泛关注。
17年回国后,课题组聚焦靶向线粒体和溶酶体功能的神经保护策略和机制研究。围绕神经损伤再生、神经退行性疾病、脑卒中等神经系统疾病的科学问题,立足于学科交叉,以结合转基因动物模型,灵长类动物模型、工程微流控系统、以及基于macro指令的高通量显微自动成像与图像分析、和前沿的细胞和分子生物学手段来探索这些疾病的发生机制。开发保护神经元的临床前溶酶体医药(Lysosomal Medicine)和线粒体医药(Mitochondrial Medicine)。后续转化研究与首都医科大学宣武医院,北京市脑血管重大疾病研究院合作进行。课题受北京市自然科学基金,国家面上项目,科技部项目,北航青年拔尖人才杰青类等支持。
主要的研究方向包括:
1)神经退行性病变和再生过程中的代谢可塑性调控机制;
2)低温低氧医学在神经系统疾病与脑保护中的研究;
3)神经元细胞器互作网络研究和药物靶点筛选。
发表文章:
1.Rongrong Han(#), yang xiaoyan(#), Xunming Ji*, Bing Zhou* (2024) Remote Ischemic Preconditioning Prevents High Altitude Cerebral Edema by Enhancing Glucose Metabolic Reprogramming. CNS neuroscience & Therapeutics. Volume30, Issue9, 2024 http://doi.org/10.1111/cns.70026
2.Hong An, Bing Zhou, Kazuhide Hayakawa, Violeta Durán Laforet, Ji-Hyun Park, Yoshihiko Nakamura, Emiri T. Mandeville, Ning Liu, Shuzhen Guo, PhD, Zhanyang Yu, Jingfei Shi, Di Wu, Wenlu Li, Eng H. Lo, and Xunming Ji*, Stroke, 2024 Volume 55, Number 7, http://doi.org/10.1161/STRO KEAHA.123.045550
3.Xiaoyan Yang, Bing Zhou* (2024) Unleashing metabolic power for axonal regeneration Trends in Endocrinology & Metabolism, 2024 27.July http://doi.org/ 10.1016 /j.tem.2024.07.001
4.Yueqi Wang, Changjian Li, Jiaming Zhuo, Hui Hui, Bing Zhou* & Jie Tian* (2023) The Detection of Divalent Iron and Reactive Oxygen Species During Ferroptosis with the Use of a Dual-Reaction Turn-On Fluorescent Probe, Molecular Imaging and Biology volume 25, pages423-434
5.YingJie Guo, et al.(2022) Small molecule agonist of mitochondrial fusion repairs mitochondrial dysfunction. Nature Chemical Biology, 2023 Jan 12.doi: 10.1038/s41589-022-01224-y.
6.Hong An(#), Bing Zhou*,xunmin ji* (2021) Mitochondrial quality control in acute ischemic stroke JCBFM. 22(11),5887 http://doi.org/ 10.1177/0271678X211046992
7.Rongrong Han(#), Jing Liang , Bing Zhou* (2021) Glucose Metabolic Dysfunction in Neurodegenerative Diseases-New Mechanistic Insights and the Potential of Hypoxia as a Prospective Therapy Targeting Metabolic Reprogramming. Int.J.Mol.Sci. 22(11),5887 http://doi.org/10. 3390 /ijms22115887
8.Jiamin Wu, Zhi Lu, Dong Jiang, Yuduo Guo, Hui Qiao, Yi Zhang, Tianyi Zhu, Yeyi Cai, Xu Zhang, Karl Zhanghao, Hao Xie, Tao Yan, Guoxun Zhang, Xiaoxu Li, Zheng Jiang, Xing Lin, Lu Fang, Bing Zhou, Peng Xi, Jingtao Fan, Li Yu, Qionghai Dai (2021) Iterative tomography with digital adaptive optics permits hour-long intravital observation of 3D subcellular dynamics at millisecond scale. Cell http://doi.org/10.1016/j.cell. 2021. 04.029
9.Jing Liang(#), Rongrong Han, Bing Zhou* (2021) Metabolic Reprogramming: Strategy for Ischemic Stroke Treatment by Ischemic Preconditioning. Biology 10(5),424; doi.org/10.3390/biology10050424
10.Xiaoyan Yang(#); Ruixuan Liu; Ying Xu; XiangYu Ma, Bing Zhou* (2021) The Mechanisms of Peripheral Nerve Preconditioning Injury on Promoting Axonal Regeneration. Neural Plasticity, doi.org/10.1155/2021/6648004
11.Huang, Z.H(#)., Feng, A.Y., Liu, J., Zhou, L., Zhou, B*., and Yu, P. (2021). Inhibitor of DNA binding 2 accelerates nerve regeneration after sciatic nerve injury in mice. Neural Regen Res 16, 2542-2548.
12.Z. Huang(#), J. Liu, J. Jin, Q. Chen, L. B. E. Shields, Zhang Y.Zhou L, Zhou B*, Yu P* (2019) Inhibitor of DNA binding 2 promotes axonal growth through upregulation of Neurogenin2. Exp Neurol. 2019;320:112966.
13.Cheng XT(#), Xie Y, Zhou B, Huang N, Tamar Farfel-Becker, Sheng ZH*(2018) Revisiting LAMP1 as a marker for degradative autophagy-lysosomal organelles in the nervous system. Autophagy, 14(8):1472-1474. (5yr IF=11.95)
14.Cheng XT(#), Xie Y, Zhou B, Huang N, Tamar Farfel-Becker, Sheng ZH* (2018). Characterization of LAMP1-labeled nondegradative lysosomal and endocytic compartments in neurons. The Journal of Cell Biology DOI: 10.1083/jcb.201711083. (5yr IF=9.88)
15.Lin MY(#), Cheng XT, Tammineni, Xie Y, Zhou B, Cai Q, Sheng ZH* (2017) Releasing syntaphilin removes stressed mitochondria from axons independent of mitophagy under pathophysiological conditions. Neuron, 94, 595-610. (5yr IF=16.09)
16.Zhou B(#), Yu P, Lin MY, Sun T, Chen YM, Sheng ZH* (2016). Facilitation of axon regeneration by enhancing mitochondria transport and rescuing energy deficits. The Journal of Cell Biology, 214(1):103-119 (封面文章, Nature杂志Research Highlights,New England Journal of Medicine发表题为"Mitochondrial Mobility and Neuronal Recovery"的文章对该研究进行专题介绍和评论,AAAS新闻平台、NIH官方网站等多家媒体新闻报道) (5yr IF=9.88) News Release: Mobilizing mitochondria may be key to regenerating damaged neurons . http://www.eurekalert.org/pub_releases/ 2016 -06/rup-mmm060716.php.
17.Xie Y(#), Zhou B(#), Lin MY, Wang S, Foust KD, and Sheng ZH* (2015). Endolysosomal Deficits Augment Mitochondria Pathology in Spinal Motor Neurons of Asymptomatic fALS Mice. Neuron, 87(2): 355-370.(#Co-first author). (5yr IF=16.09) (一作或共一)NIH Government News Releases: Neurons' broken machinery piles up in ALS.http://www.nih.gov/news-events/news-releases/neurons-broken-machinery-piles-als
18.Xie Y(#), Zhou B, Lin MY, and Sheng ZH*(2015). Progressive endolysosomal deficits impair autophagic clearance beginning at early asymptomatic stages in fALS mice. Autophagy, 11(10): 1934-1936. (5yr IF=11.95)
19.Cheng XT(#), Zhou B, Lin MY, Cai Q, and Sheng ZH* (2015). Axonal autophagosomes recruit dynein for retrograde transport through fusion with late endosomes. The Journal of Cell Biology, 209(3): 377-386.(封面文章) (5yr IF=9.88)
20.Cheng XT(#), Zhou B, Lin MY, Cai Q, and Sheng ZH* (2015), Axonal autophagosomes use the ride-on service for retrograde transport toward the soma. Autophagy, 11(8): 1434-1436. (5yr IF=11.95)
21.Wen J(#), Yang HB, Zhou B, Lou HF, and Duan S*. (2013). β-Catenin is critical for cerebellar foliation and lamination. PloS One, 8(5): e64451. (5yr IF=3.53)
22.Zhou B(#), Cai Q, Xie Y, and Sheng ZH*. (2012). Snapin recruits dynein to BDNF-TrkB signaling endosomes for retrograde axonal transport and is essential for dendrite growth of cortical neurons. Cell Reports, 2(1): 42-51. (5yr IF=8.12) (一作或共一)
23.Zhou B(#), Zhu YB(#), Lin L(#), Cai Q, and Sheng ZH*. (2011). Snapin deficiency is associated with developmental defects of the central nervous system. Bioscience Reports, 31(2): 151-158. (5yr IF=2.51)
24.Tong XP(#), Li XY, Zhou B, Shen W, Zhang ZJ, Xu TL, and Duan S*. (2009). Ca(2+) signaling evoked by activation of Na(+) channels and Na(+)/Ca(2+) exchangers is required for GABA-induced NG2 cell migration. The Journal of Cell Biology, 186(1): 113-128. (5yr IF=9.88)
25.Li H(#), Chen G, Zhou B, and Duan S*. (2008). Actin filament assembly by myristoylated alanine-rich C kinase substrate-phosphatidylinositol-4,5 -diphosphate signalling is critical for dendrite branching. Molecular Biology of the Cell, 19(11): 4804-4813. (5yr IF=4.60)
26.Wang XB(#), Zhou B, Yin CC, Lin Q, and Huang HL*. (2004). A new approach for rapidly reshaping single-chain antibody in vitro by combining DNA shuffling with ribosome display. Journal of Biochemistry, 136(1): 19-28. (5yr IF=2.79)
撰写著作:
1. Zhou B, Lin MY, Sun T, Knight AL, and Sheng ZH. (2014). Characterization of mitochondrial transport in neurons. Methods in enzymology,547: 75-96.
2. 周炳. 神经胶质细胞对突触功能的调节,《神经元突触传递的细胞和分子生物学》第14章,2008年, 上海科学技术出版社
承担项目:
1.北京市自然科学基金重点项目,跨尺度多模态计算光场活体显微成像技术研究及其在脑卒中研究中的应用 2024.07-2028.06,300万(骨干主持,25万)
2.北京市亦城合作发展基金会,应用罗沙司他和美托查酮联合靶向线粒体代谢耦合治疗肌萎缩侧索硬化症的研究 2024.01-2024.12,5万(项目负责人)
3.国家自然科学基金面上项目,果糖-丝氨酸-线粒体代谢通路对抗缺血性卒中的效应和时空机制研究,2023.01-2026.12,52万(项目负责人)
4.北京市自然科学基金-海淀原始创新联合基金,基于糖代谢-线粒体稳态重塑治疗肌萎缩侧索硬化症的研究,2023.01-2025.12, 29.3万(项目负责人)
5.国家自然科学基金面上项目,靶向溶酶体功能和轴浆线粒体动态平衡对ALS运动神经元能量代谢瀑布反应的调控研究,2020.01-2023.12 ,55万(项目负责人)
6.北京市自然科学基金面上项目,神经元线粒体应激对急性高原病相关脑水肿的影响及其作用机制研究,2019.01-2021.12 ,20 万(项目负责人)
7.科技部蛋白质机器与生命过程调控重点专项,线粒体和溶酶体稳态维持的蛋白质机器及其在神经退行性疾病中的作用,2019.07-2024.06 ,2400万(骨干主持,216万)
8.军队后勤开放研究科研专项,高原*****控制策略,1588万(骨干主持,100万)
9.北京亚洲成人在线一二三四五六区青年拔尖人才杰青类,线粒体医学与神经疾病康复,2018.09-2022.12 ,50 万(项目负责人)
10.北京亚洲成人在线一二三四五六区医工交叉创新研究院青年拔尖人才杰青类,神经系统的时空代谢可塑性与疾病,2018.06-2022.12 ,50 万(项目负责人)
11.北京亚洲成人在线一二三四五六区青年科学家团队,脑卒中等神经系统疾病的发病机理、检测*、诊断与康复的研究,100万(骨干主持,15万)
12.动脉狭窄影像视网膜血管特征、图像病变分割及静脉狭窄代谢分型研究,2023.09-2024.12 ,33.5万(项目负责人)
13.线粒体代谢改变在低氧诱导脾脏新型红系来源免疫调节细胞生成中的作用及机制,2023.09-2024.12 ,15万(项目负责人)
14.南京脑观象台线粒体代谢通路对抗缺血性卒中的效应研究,2022.1-2023.12,14万(项目负责人)
15.北京亚洲成人在线一二三四五六区大数据与精准医疗中心医工百人基金,线粒体医学,2018.06-2020.12 ,20万(项目负责人)
16.北京亚洲成人在线一二三四五六区大数据与精准医疗中心,神经疾病与精准医学,2017.06-2019.12 ,600万(骨干主持,80万)
学术任职及奖励:
中国生物物理学会膜理事会 委员(2018-)
中国生物物理学会低氧与健康分会 理事
美国华人生物医药科技协会 (CBA-USA) 理事
美国国立卫生研究院FARE学会 委员 (2012-2016)
美国神经科学学会 会员 (Society for Neuroscience, 2009-)
美国细胞生物学学会 会员 (The American Society for Cell Biology,2011-)
美国心脏与卒中协会 会员 (AHA/ASA, 2018-)
中国老年学和老年医学学会转化医学分会常务委员(2021-)
中国水利电力医学科学技术学会高原医学分会委员(2021-)
北京亚洲成人在线一二三四五六区 科创部副部长(2022-)
北京神经科学学会脑静脉病变与高颅压专业委员会(2023-)
北京市中关村科学城管委会 产业促进三处挂职副处长(2024-)
北京市医药健康大基金 产业顾问(2024-)
北京亚洲成人在线一二三四五六区分析测试中心 责任教授
中国人民解放军总医院第七医学中心 专家委员会委员
美国国立卫生健康研究院(NIH) Visiting Fellow & Research Fellow
上海交通大学 医学神经生物
兰州大学 体细胞遗传
兰州大学 生物化学
NIH Research Fellow
NIH Visiting Fellow